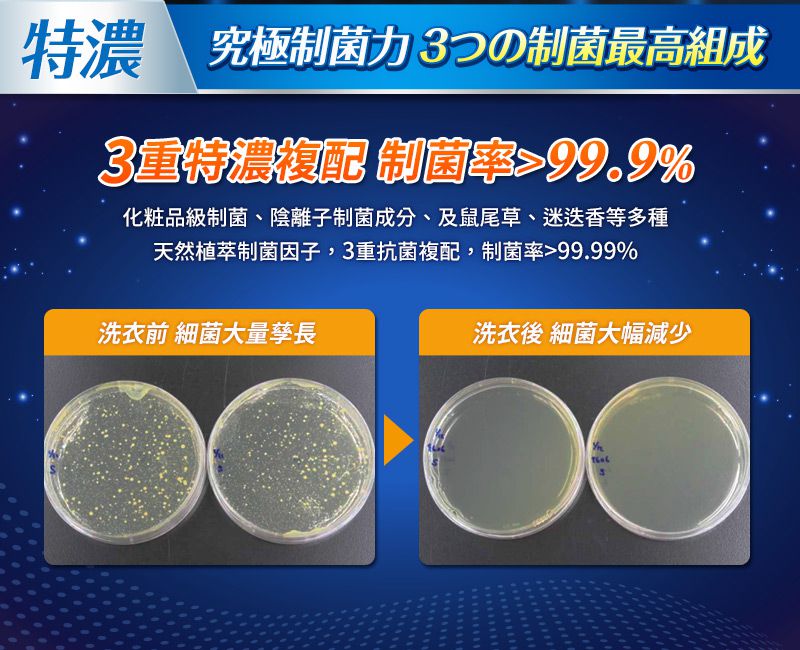
毛寶 maobao - 葳香抗菌洗衣精-防蟎極淨-2000g

首載 App 現領 $ 100 折價券
 ( 10000+ )
( 10000+ )
1/1
商品特色
實驗證實,有效洗淨4大病毒
究極防螨潔淨力,1滴蘊含過敏原去除力
究極制菌力3重特濃複配,制菌率99.9%
鳶尾香子蘭,國際調香師精心調製

口碑嚴選

正品保證

加密付款

7天鑑賞
付款
信用卡・LINE Pay・街口支付・先享後付・ATM・貨到付款
配送
宅配
免運
超商取貨
免運
註冊新會員立即領首購免運券
介紹












- 實驗證實,有效洗淨4大病毒
採用美國EPA公告有效的獨特病毒洗淨因子,並經台灣知名大學研究中心檢驗可洗淨冠狀病毒(229E)、A型流感(H1N1)、B型流感、腸病毒,衣物潔淨、防護一次搞定才能真安心!
- 究極防螨潔淨力,1滴蘊含過敏原去除力
澳洲天然尤加利精油及植物來源洗淨因子複配組成,深層洗淨汗漬、皮脂、污垢,阻斷塵蟎食物鏈,預防孳生,不需經強烈日曬,也能達到防蟎功效。
- 究極制菌力3重特濃複配,制菌率>99.9%
化粧品級制菌因子、陰離子制菌成分、及鼠尾草、迷迭香等多種天然植萃制菌因子,3重抗菌複配,有效抑制大腸桿菌、金黃色葡萄球菌、沙門氏菌等常見壞菌。
- 鳶尾香子蘭,國際調香師精心調製
彷彿耀眼的綠洲,清甜的柑橘點綴著石榴的酸澀,搭配著象徵著正能量的鳶尾花香,尾韻帶出香草的溫暖,完美融合了酸甜,引領出令人愉悅的正能量。

看更多

